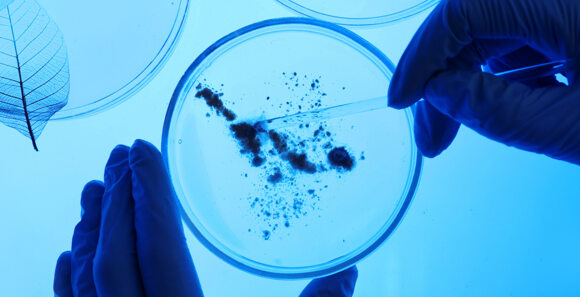

Navigating compliance in life sciences: Increased demand for digitalization increases the need for lean but compliant computerized systems validation.
In the life sciences industry, meeting diverse requirements, from customer demands to strict adherence to laws, standards, and guidelines, is crucial. At BearingPoint, we understand the complexity imposed by regulations such as GxP, FDA 21 CFR Part 11, ISO 13485, MDR, and IVDR. Part of that encompasses validating computerized systems, including ERP systems, and the qualification of the underlying IT infrastructure. Our clients face a variety of questions that require flexible solutions and approaches. BearingPoint, together with you, will find lean, compliant, and business-oriented answers.
Our clients must ensure that computer systems in regulated areas, such as pharmaceuticals, medical devices, healthcare, and life sciences, meet regulatory requirements and operate reliably. Several challenges are associated with computerized systems validation, from digital transformation to reconciling compliance and innovation. Rapid technological advancements present challenges in validating and maintaining compliance with newer systems. Adapting validation processes to emerging technologies like cloud computing, artificial intelligence, and the Internet of Things (IoT) can be particularly complex.
As the life science industry embarks on a journey toward digitalization, how do our clients stay compliant without stifling innovation?
We assist clients in finding customized solutions by leveraging our profound expertise in consulting and providing relevant products to address their challenges effectively. Our goal is to facilitate computerized systems validation to help our clients focus on what is essential: their patients’ health.
In a rapidly evolving industry, we consider ourselves to be a facilitator for compliance. Join us on a journey that aligns innovation with compliance, the future of the GxP-regulated industry.
- Amplified technical expertise: Our experts are trained in ERP implementation and computerized systems validation for process facilitation.
- Advancing digitalization: We take your digitalization to the next level with a compliant, resource-optimized, and profit-oriented approach.
- Global perspective: BearingPoint has over 6,000 experts across many areas and industries. A specialist is always available to support you with any upcoming integrative issues or customer-specific challenges.
- Market access: With us, computerized systems validation does not hinder innovation or market access.
- Industry expertise: Gain access to valuable insights from validation projects from many industry branches.
Join us in facilitating compliance to ensure your patients’ safety. Contact us today.
Would you like more information?
If you want to get more information about this subject please get in touch with our experts who would be pleased to hear from you.